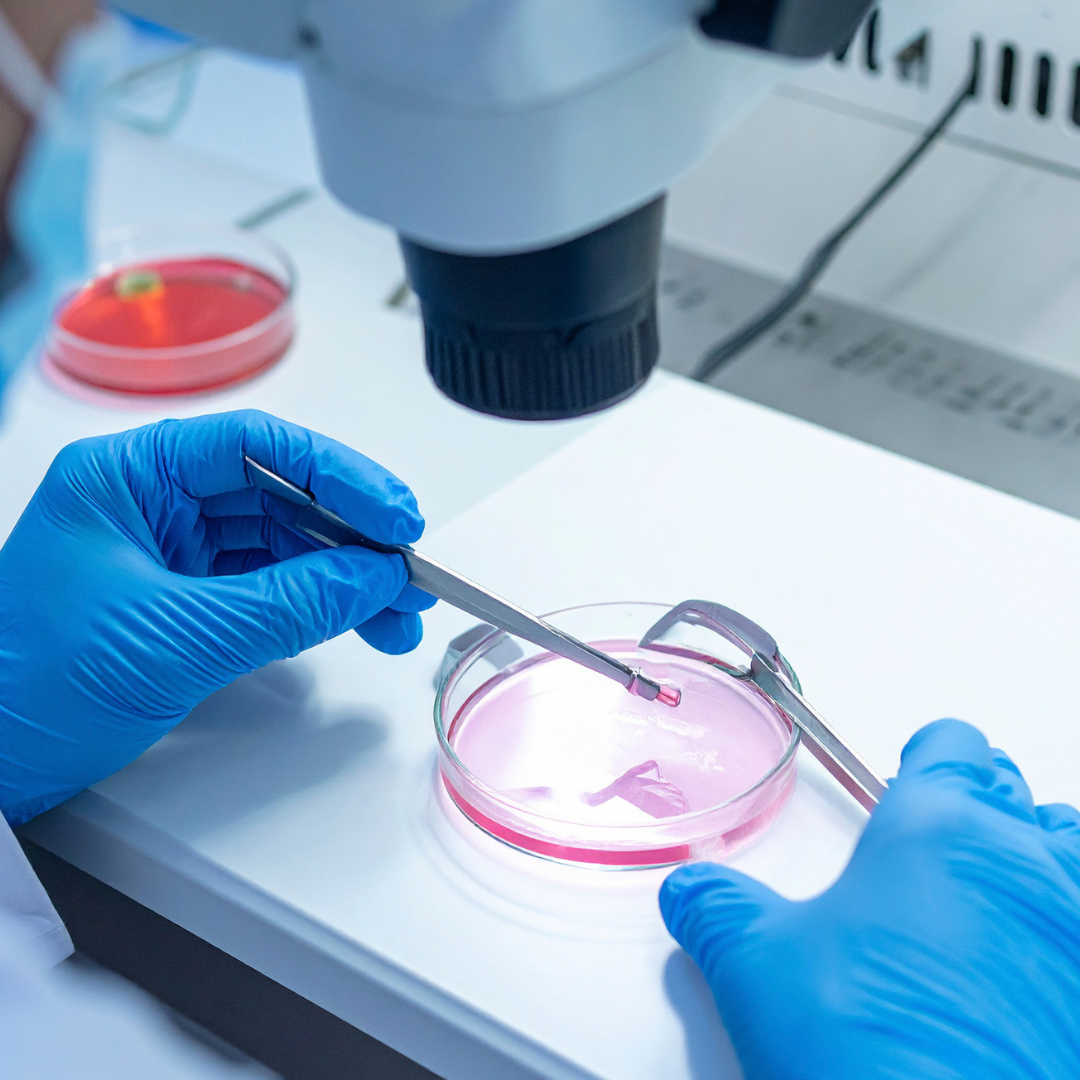

IVF Sucess journal
IVF Sucess journal
Regular price
$4.95
Regular price
$4.95
Sale price
Unit price
/
per
✨ Perfect for special events & dates
❤️ Silky smooth on your skin
✅ Over 5,000+ Happy Customers
Couldn't load pickup availability
 
Sizing Chart
| Size | Chest | Length | Shoulder |
|---|---|---|---|
| S | 95cm | 61cm | 44cm |
| M | 102cm | 66cm | 46cm |
| L | 106cm | 71cm | 48cm |
| XL | 111cm | 74cm | 51cm |
Give your customers further information about choosing the correct size.